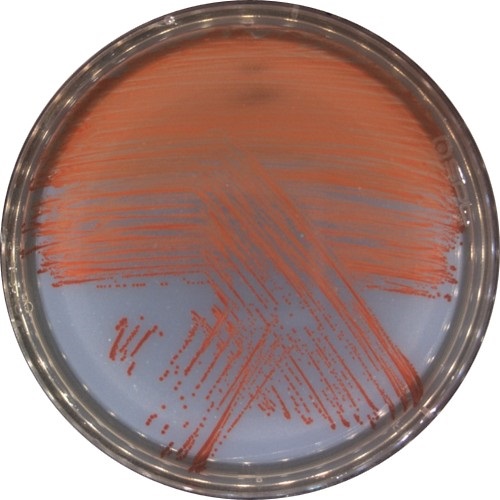

|
±âÈÄ¿¡³ÊÁöȯ°æºÎ »êÇÏ ±¹¸³È£³²±Ç»ý¹°ÀÚ¿ø°ü(°üÀå ¹ÚÁø¿µ)Àº ÇØ¾ç ȯ°æ¿¡¼ ºÐ¸®ÇÑ ½ÅÁ¾ ºñºê¸®¿À±ÕÀÌ °·ÂÇÑ Ãµ¿¬ Ç×±Õ¹°Áú ‘ÇÁ·ÎµðÁö¿À½Å(prodigiosin)’À» »ý¼ºÇÏ´Â »ç½ÇÀ» È®ÀÎÇϰí, 11¿ù 24ÀÏ ÇØ´ç ±â¼úÀ» ƯÇã Ãâ¿øÇß´Ù°í ¹àÇû´Ù.
ÇÁ·ÎµðÁö¿À½ÅÀº ÀÏºÎ ÇØ¾ç·Åä¾ç ¹Ì»ý¹°¿¡¼ ¼Ò·® »ý¼ºµÇ´Â õ¿¬ Àû»ö »ö¼Ò·Î, Ç×±Õ, Ç׿°Áõ, Ç×¾Ï È°¼ºÀ» °®´Â À¯¿ëÇÑ »ý¸®È°¼º ¹°Áú·Î ¾Ë·ÁÁ® ÀÖ´Ù.
| |
|
|
| ¡ã ½ÅÁ¾ ºñºê¸®¿À VRS2 ±ÕÁÖ¸¦ ¹è¾çÇÑ »çÁø(Àû»öÀÇ ÇÁ·ÎµðÁö¿À½ÅÀ» »ý¼ºÇÔ) |
¿¬±¸ÁøÀÌ È®º¸ÇÑ ½ÅÁ¾ ºñºê¸®¿À VRS2(HNIBR-BC3459) ±ÕÁÖ´Â ÇÁ·ÎµðÁö¿À½ÅÀ» ¾ÈÁ¤ÀûÀ¸·Î »ý¼ºÇϴ Ư¡À» º¸¿´À¸¸ç, ƯÁ¤ º´¿ø¼º ºñºê¸®¿À±Õ¿¡ ´ëÇÑ Ç×±Õ È°¼ºÀ» ³ªÅ¸³» ģȯ°æ »ý¹°Á¦Àç·Î¼ÀÇ È°¿ë °¡´É¼ºÀÌ È®ÀεƴÙ.
| |
 |
|
| ¡ã Åõ¸íÇÑ ºÎºÐ(Ŭ¸®¾îÁ¸)Àº ÇÁ·ÎµðÁö¿À½ÅÀÇ Ç×±Õ È°¼ºÀ¸·Î ÀÎÇØ ±ÕÀÇ ¼ºÀåÀÌ ¾ïÁ¦µÈ ¿µ¿ª º¸¿©ÁÖ´Â »çÁø |
ºñºê¸®¿ÀÁõÀº ¾ç½Ä ¾î·ù¿Í ÆÐ·ù¿¡¼ ¹Ýº¹ÀûÀ¸·Î ¹ß»ýÇÏ´Â ´ëÇ¥ÀûÀÎ ¼¼±Õ¼º Áúº´À¸·Î, ±¹³» ¼ö»ê¾ç½Ä »ê¾÷ÀÇ »ý»ê¼º ÀúÇÏ¿Í °æÁ¦Àû ÇÇÇØ¸¦ ÃÊ·¡ÇؿԴÙ. ¿¬±¸ÁøÀº VRS2 ±ÕÁַκÎÅÍ ÃßÃâÇÑ »ö¼Ò°¡ ÁÖ¿ä ºñºê¸®¿ÀÁõ ¿øÀαÕÀÎ ºñºê¸®¿À ÇϺ£ÀÌ, ºñºê¸®¿À ¾È±Ö¶ó·ë, ºñºê¸®¿À ¾Ë±â³î¸®Æ¼Äí½º, ºñºê¸®¿À ºÒ´ÏÇÇÄí½º, ºñºê¸®¿À ÆÄ¶óÇì¸ô¸®Æ¼Äí½º »Ó¸¸ ¾Æ´Ï¶ó Ȳ»öÆ÷µµ»ó±¸±Õ, Ç¥ÇÇÆ÷µµ»ó±¸±Õ µî ÀϺΠÀÎü º´¿ø±Õ¿¡ ´ëÇØ¼µµ Ç×±Õ È°¼ºÀ» º¸¿´´Ù°í ¹àÇû´Ù.
±¹¸³È£³²±Ç»ý¹°ÀÚ¿ø°üÀº ±¹³» ¼¶°ú ¿¬¾È Áö¿ªÀÇ »ý¹°ÀÚ¿øÀ» ü°èÀûÀ¸·Î ¹ß±¼Çϰí Á¶»çÇÏ¿© »ý¹°ÁÖ±ÇÀÇ Á¶±â È®¸³°ú °íºÎ°¡°¡Ä¡ »ý¹°¼ÒÀç âÃâÀ» ÇÔ²² ÃßÁøÇϰí ÀÖ´Â ±¹°¡ ¿¬±¸±â°üÀÌ´Ù.
¼ÛÇý¼± ÀüÀÓ¿¬±¸¿øÀº “½ÅÁ¾ ºñºê¸®¿À±Õ VRS2°¡ »ý»êÇÏ´Â ÇÁ·ÎµðÁö¿À½ÅÀº ±âÁ¸ÀÇ ÈÇÐÀû ¶Ç´Â Ç×»ýÁ¦ ±â¹Ý ¹æÁ¦¹ýÀÇ ÇѰ踦 º¸¿ÏÇÒ ¼ö ÀÖ´Â À¯¸ÁÇÑ ´ë¾È ¹°Áú”À̶ó¸ç, “À̸¦ Ȱ¿ëÇÑ Ä£È¯°æ ¼ö»ê¿ë »ý¹°Á¦Á¦´Â Ç×»ýÁ¦ »ç¿ëÀ» ÁÙÀÌ¸é¼ ¾î·ù¿Í ÆÐ·ùÀÇ ºñºê¸®¿ÀÁõ ¿¹¹æ ¹× °ü¸® ±â¼ú·Î ¹ßÀüÇÒ ¼ö ÀÖ´Ù”¶ó°í ¼³¸íÇß´Ù.
À̹ø ¿¬±¸´Â ¾ç½Ä ȯ°æ¿¡¼ ¹ß»ýÇÏ´Â ¼ö»ê Áúº´ ¹®Á¦¸¦ ÇØ°áÇÒ ¼ö ÀÖ´Â »õ·Î¿î Á¢±Ù¹ýÀ¸·Î Æò°¡µÇ¸ç, ÇâÈÄ Ä£È¯°æ ¼ö»ê Ç×±Õ ¼ÒÀç °³¹ß ¹× ÀÎü¿ë Ç×±ÕÁ¦ ±âÃÊ ¼ÒÀç·Îµµ È®ÀåµÉ °¡´É¼ºÀÌ ±â´ëµÈ´Ù. |